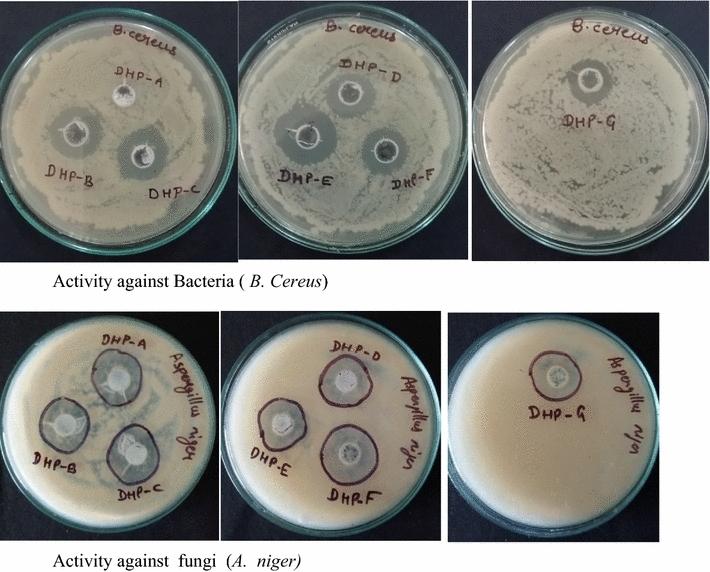

一些新型酰腙类分子杂化物作为抗疟和抗菌剂的设计、合成、构象及分子对接研究
Design, synthesis, conformational and molecular docking study of some novel acyl hydrazone based molecular hybrids as antimalarial and antimicrobial agents.
作者信息
Kumar Parvin, Kadyan Kulbir, Duhan Meenakshi, Sindhu Jayant, Singh Vineeta, Saharan Baljeet Singh
机构信息
Department of Chemistry, Kurukshetra University, Kurukshetra, 136119, India.
S D (PG) College, Panipat, 132103, India.
出版信息
Chem Cent J. 2017 Nov 14;11(1):115. doi: 10.1186/s13065-017-0344-7.
BACKGROUND
Acyl hydrazones are an important class of heterocyclic compounds promising pharmacological characteristics. Malaria is a life-threatening mosquito-borne blood disease caused by a plasmodium parasite. In some places, malaria can be treated and controlled with early diagnosis. However, some countries lack the resources to do this effectively.
RESULTS
The present work involves the design and synthesis of some novel acyl hydrazone based molecular hybrids of 1,4-dihydropyridine and pyrazole (5a-g). These molecular hybrids were synthesised by condensation of 1,4-dihydropyridin-4-yl-phenoxyacetohydrazides with differently substituted pyrazole carbaldehyde. The final compound (5) showed two conformations (the major, E, s-cis and the minor, E, s-trans) as revealed by NMR spectral data and further supported by the energy calculations (MOPAC2016 using PM7 method). All the synthesised compounds were screened for their in vitro antimalarial activities against chloroquine-sensitive malaria parasite Plasmodium falciparum (3D7) and antimicrobial activity against Gram positive bacteria i.e. Bacillus cereus, Gram negative bacteria i.e. Escherichia coli and antifungal activity against one fungus i.e. Aspergillus niger [corrected]. All these compounds were found more potent than chloroquine and clotrimazole, the standard drugs.
CONCLUSIONS
In vitro antiplasmodial IC value of the most potent compound 5d was found to be 4.40 nM which is even less than all the three reference drugs chloroquine (18.7 nM), pyrimethamine (11 nM) and artimisinin (6 nM). In silico binding study of compound 5d with plasmodial cysteine protease falcipain-2 indicated the inhibition of falcipain-2 as the probable reason for the antimalarial potency of compound 5d. All the compounds had shown good to excellent antimicrobial and antifungal activities.
背景
酰腙是一类具有重要药理特性的杂环化合物。疟疾是一种由疟原虫寄生虫引起的危及生命的蚊媒血液疾病。在一些地方,早期诊断可对疟疾进行治疗和控制。然而,一些国家缺乏有效开展此项工作的资源。
结果
目前的工作涉及设计和合成一些新型的基于酰腙的1,4 - 二氢吡啶和吡唑分子杂化物(5a - g)。这些分子杂化物是通过1,4 - 二氢吡啶 - 4 - 基 - 苯氧基乙酰肼与不同取代的吡唑甲醛缩合而成。核磁共振光谱数据显示最终化合物(5)呈现两种构象(主要的E,s - 顺式和次要的E,s - 反式),能量计算(使用PM7方法的MOPAC2016)进一步证实了这一点。对所有合成化合物针对氯喹敏感的疟原虫恶性疟原虫(3D7)进行了体外抗疟活性筛选,以及针对革兰氏阳性菌蜡样芽孢杆菌、革兰氏阴性菌大肠杆菌的抗菌活性筛选,还有针对一种真菌黑曲霉的抗真菌活性筛选。发现所有这些化合物比标准药物氯喹和克霉唑更有效。
结论
发现最有效的化合物5d的体外抗疟IC值为4.40 nM,甚至低于所有三种参考药物氯喹(18.7 nM)、乙胺嘧啶(11 nM)和青蒿素(6 nM)。化合物5d与疟原虫半胱氨酸蛋白酶恶性疟原虫蛋白酶 - 2的计算机模拟结合研究表明,抑制恶性疟原虫蛋白酶 - 2可能是化合物5d具有抗疟效力的原因。所有化合物均表现出良好至优异的抗菌和抗真菌活性。